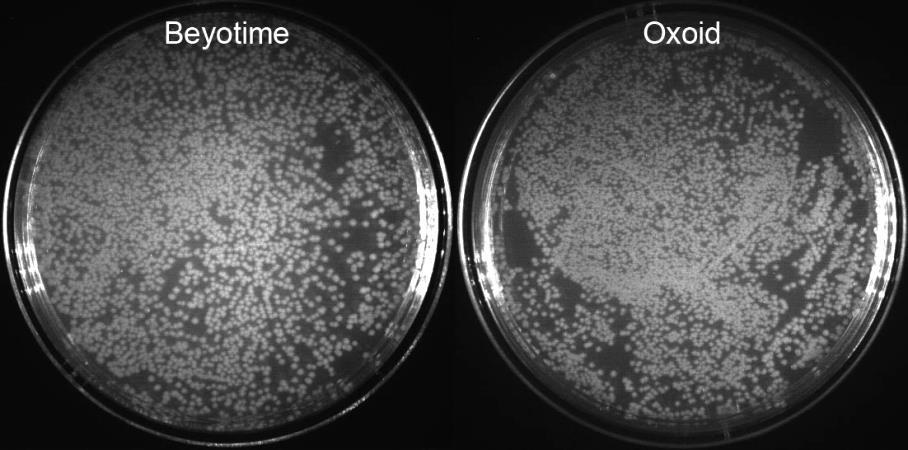

细菌养得好,即用型LB培养基/平板少不了!
LB 培养基是最广泛使用的细菌生长培养基,主要包括胰蛋白胨、酵母膏、氯化钠等成分,分为液态和固态两种形式,碧云天为大家提供一系列高品质即用型LB培养基/平板产品,为您的细菌培养保驾护航!
选择列表
| 产品编号 | 产品名称 | 产品形式 |
| ST163 | LB培养基(不含抗生素) | 即用型液体 |
| ST165 | LB培养基(含氨苄青霉素) | 即用型液体 |
| ST167 | LB培养基(含卡那霉素) | 即用型液体 |
| ST164 | LB琼脂平板(不含抗生素) | 即用型平板 |
| ST166 | LB琼脂平板(含氨苄青霉素) | 即用型平板 |
| ST168 | LB琼脂平板(含卡那霉素) | 即用型平板 |
产品效果
碧云天生产的LB培养基,与用国外Oxoid的胰蛋白胨和酵母膏配制的LB相比,色泽基本一致,用于DH5α和TG1细菌培养测试时,细菌的生长曲线完全一致:

图1. 碧云天的BeyoPure™ LB Broth (premixed powder)配制的LB培养基与用国外Oxoid的胰蛋白胨和酵母膏配制的LB用于细菌培养的效果图。上图为大肠杆菌DH5α(A)和TG1(B)在碧云天和Oxoid产品配制的LB培养基中的生长曲线比较。
碧云天生产的LB琼脂培养基,与用国外Oxoid的胰蛋白胨和酵母膏配制的LB相比,色泽基本一致,用于DH5α和TG1细菌培养测试时,菌落的生长效果完全一致:
图2. 碧云天的BeyoPure™ LB Broth with Agar (premixed powder)配制的LB琼脂培养基与用国外Oxoid的胰蛋白胨和酵母膏配制的LB琼脂培养基,培养的大肠杆菌DH5α菌落形态图。培养条件和培养时间完全相同。
产品特点
- 超高品质:本系列产品采用高品质原料配置,并经超滤处理,确保了产品的纯度、均一性和溶解性,效果与国外知名品牌一致;
- 多种选择:本系列产品提供有预混粉末、即用型液体培养基和即用型琼脂平板,以及提供不含抗生素、含氨苄青霉素(Ampicillin)和含卡那霉素(Kanamycin)3款产品以满足不同抗性细菌培养需求;
- 性价比高:超高性价比,为用户节省时间的同时节约经费!
产品信息
| 产品编号 | 产品名称 | 包装 | 产品价格 |
| ST163-500ml | LB培养基(不含抗生素) | 500ml | |
| ST165-500ml | LB培养基(含氨苄青霉素) | 500ml | |
| ST167-500ml | LB培养基(含卡那霉素) | 500ml | |
| ST164-10pcs | LB琼脂平板(不含抗生素) | 10皿/包 | |
| ST164-40pcs | LB琼脂平板(不含抗生素) | 10皿/包;4包/盒 | |
| ST166-10pcs | LB琼脂平板(含氨苄青霉素) | 10皿/包 | |
| ST166-40pcs | LB琼脂平板(含氨苄青霉素) | 10皿/包;4包/盒 | |
| ST168-10pcs | LB琼脂平板(含卡那霉素) | 10皿/包 | |
| ST168-40pcs | LB琼脂平板(含卡那霉素) | 10皿/包;4包/盒 |
相关产品
| 产品编号 | 产品名称 | 包装 | 产品价格 |
| ST004D | Agar(琼脂粉) | 100g | |
| ST004E | Agar(琼脂粉) | 500g | |
| ST007 | Ampicillin | 5g | |
| ST008 | Ampicillin (100mg/ml, 1000X) | 5ml | |
| ST101 | Kanamycin | 1g | |
| ST102 | Kanamycin (10mg/ml, 1000X) | 5g | |
| ST800 | Tryptone/胰蛋白胨 | 500g | |
| ST802 | BeyoPure™ Tryptone/BeyoPure™胰蛋白胨 | 500g | |
| ST156 | BeyoPure™ LB Broth (premixed powder) | 10瓶共5升 | |
| ST158 | BeyoPure™ LB Broth with Agar (premixed powder) | 10瓶共5升 | |
| ST961-5L | LB琼脂平板(含卡那霉素) | 10×500ml | |
| ST963-5L | BeyoPure™ YPD Broth with Agar (premixed powder) | 10×500ml | |
| ST965-500ml | BeyoPure™ YPD Broth (YPD肉汤培养基) | 500ml | |
| ST968 | Yeast extract/酵母膏 | 500g | |
| ST969 | BeyoPure™ Yeast Extract/BeyoPure™酵母膏 | 500g | |
| FSP014-100pcs | BeyoGold™一次性L型涂布棒(独立纸塑包装, 无菌) | 1支/袋, 100袋/包 | |
| FSP014-1000pcs | BeyoGold™一次性L型涂布棒(独立纸塑包装, 无菌) | 1支/袋, 100袋/包, 10包/箱 |
